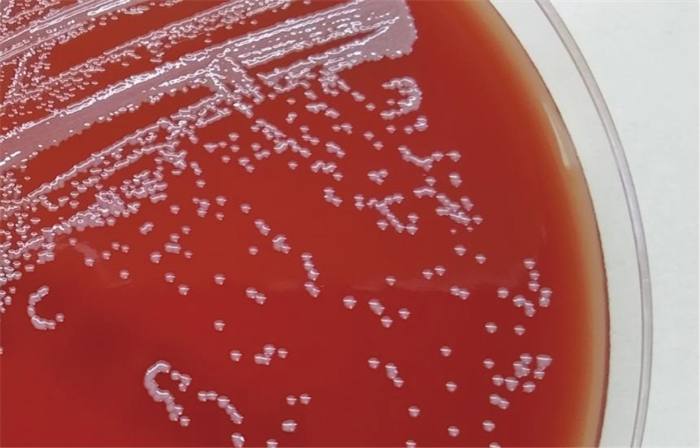

2. 复旦大学附属上海市第五人民医院院感科,上海 200240
2. Department of Nosocomial Infection Prevention and Control, Shanghai Fifth People's Hospital, Fudan University, Shanghai 200240, China
当实验室通过自动生化鉴定系统将细菌鉴定为洋葱伯克霍尔德菌,但体外药敏试验提示对多数抗菌药物敏感时,须考虑到草螺菌错误识别的可能。以传统生化反应为基础的细菌鉴定系统对草螺菌缺乏鉴定能力,基质辅助激光解吸电离飞行时间质谱(matrix-assisted laser desorption ionization-time of flight mass spectrometer,MALDI-TOF MS)和16S rRNA基因测序仅能鉴定到属,导致对草螺菌流行率和临床危害的低估。本研究报道了1例哈特草螺菌经胃肠道感染导致脓毒症的诊疗经过,以期加深实验室和临床对哈特草螺菌的认识。
1 病例介绍患者女,76岁,因“直肠腺癌术后化疗随访检查”被收入胃肠外科病房。既往史:慢性胃炎4年,腔隙性脑梗死2年。入院第3 d,患者进食自带食物后突发恶心、呕吐和高热,体温高达40 ℃。检查结果:白细胞0.7×10 9 /L,活化部分凝血活酶时间76.8 s,血糖3.2 mmol/L,血钾2.7 mmol/L,血钠136 mmol/L,血钙1.9 mmol/L,降钙素原13.75 μ g/L,白介素6为5 716.2 ng/L,C反应蛋白86 mg/L,γ干扰素2 503.7 ng/L,肿瘤坏死因子>6 615.7 ng/L,血液检出哈特草螺菌,尿液检出大肠埃希菌(>10万cfu/mL),粪便检出大量肺炎克雷伯菌和少量哈特草螺菌,未检出沙门菌、志贺氏菌,尿液中白细胞2+/HPF、红细胞+/HPF、亚硝酸盐2+,粪便常规、隐血、轮状病毒和腺病毒相关指标均为阴性,肝功能、肾功能和甲状腺功能未见明显异常。临床诊断:急性胃肠炎、全身炎症反应综合征、脓毒症和感染性休克。临床给予复方氨林巴比妥注射液2 mL退热,人粒细胞刺激因子75 μ g以促进粒系分化,冷沉淀凝血因子4个单位、血浆200 mL以改善凝血功能,补充平衡液提升血容量和维持电解质平衡治疗,抗感染治疗使用左氧氟沙星0.5 g每日一次静脉滴注,持续2 d,后调整为哌拉西林-他唑巴坦4.5 g每8 h一次静脉滴注,持续8 d,效果显著,复查血培养结果为阴性,粪便未检出哈特草螺菌,尿液未检出细菌,患者病情稳定后出院。
2 病原学鉴定 2.1 生化鉴定血培养阳性培养物直接涂片见革兰氏阴性弯曲杆菌,如图 1所示,哥伦比亚血琼脂在体积分数5% CO2、35 ℃环境中培养24 h,见灰白色圆形、半透明、凸起、无溶血环的小菌落,如图 2所示,接种环挑起菌落有黏稠感,氧化酶阳性,触酶阳性,脲酶阳性,不发酵乳糖。使用Vitek 2 Compact细菌鉴定仪(法国生物梅里埃公司)GN卡片鉴定,结果为洋葱伯克霍尔德菌(匹配度91%)。

|
| 图 1 显微镜下革兰氏染色呈弯曲形态的哈特草螺菌 Fig. 1 A curved form of H. huttiense after Gram's stain observed using a microscope |
|
| 图 2 哥伦比亚血琼脂上的哈特草螺菌(培养时间为24 h) Fig. 2 H. huttiense on Columbia blood agar (incubated for 24 h) |
挑取培养24 h的新鲜菌落,采用直接转移法制备样本,使用Microflex LT质谱仪(德国布鲁克公司)重复鉴定20次,结果为哈特草螺菌(分值2.137± 0.074)或aquaticum草螺菌(分值1.916±0.136)。
2.3 分子生物学鉴定采用水煮法提取DNA模板,对16S rRNA基因(27F:5’-AGAGTTTGATCATGGCTCAG-3’, 1492R: 5’-TACGGCTACCTTGTACGACTT-3’, 目标片段1 465 bp,反应参数:96 ℃ 3 min;96 ℃ 30 s,58 ℃ 30 s,72 ℃ 1 min,35个循环;72 ℃ 10 min)[1]和rpoB基因(VIC4:5’-GGCGAAATGGC-DGARAACCA-3’, VIC6: 5’-GARTCYTCGAA-GTGGTAACC-3’, 目标片段约1 050 bp,反应参数:94 ℃ 90 s;94 ℃ 10 s,45 ℃ 20 s,72 ℃ 50 s,35个循环;72 ℃ 5 min)[2]进行聚合酶链反应(polymerase chain reaction,PCR)扩增,PCR产物经10 g/L琼脂糖凝胶电泳确认,委托上海生工生物公司使用ABI 3739XL DNA测序仪(美国赛默飞世尔科技公司)进行一代测序,测序结果与美国国家生物技术信息中心GenBank数据库进行比对。16S rRNA基因序列比对结果为哈特草螺菌(匹配率99.6%,MH283846.1)、aquaticum草螺菌(匹配率99.39%,KY124204.1)或camelliae草螺菌(匹配率98.8%,MK119980.1),rpoB基因序列比对结果为哈特草螺菌(匹配率99.57%,EU024255.1)。以洋葱伯克霍尔德菌16S rRNA基因为外类群,对草螺菌16S rRNA基因序列使用邻接法进行比对计算遗传距离(p-distance),构建系统进化树,如图 3所示。

|
| 图 3 基于草螺菌16S rRNA基因序列采用邻接法构建的系统进化树 Fig. 3 Neighbor-joining phylogenetic tree based on 16S rRNA gene sequences of H. huttiense |
对血液和粪便来源的哈特草螺菌进行ERIC-PCR(ERIC-F: 5’-AAGTAAGT-GACTGGGGTGAGCG-3’, ERIC-R: 5’-ATG-TAAGCTCCTGGGGATTCAC-3’,反应参数:94 ℃ 10 min;94 ℃ 1 min,48 ℃ 1 min,72 ℃ 5 min,35个循环;72 ℃ 10 min)[3],采用去离子水作为无模板阴性对照,肺炎克雷伯菌的2种标准菌株ATCC BAA-1705和ATCC 700603作为阳性对照,PCR产物使用10 g/L琼脂糖凝胶进行电泳(2.5 V/cm),使用G: BOX HR-680X全自动凝胶成像系统(英国Syngene公司)进行拍照,结果如图 4所示。

|
| 注:泳道1号到5号分别是来自血液、粪便的哈特草螺菌、无模板阴性对照、ATCC BAA-1705和ATCC 700603;DNA Marker片段大小已在左侧标记。 Lanes 1 to 5 were H. huttiense from blood, H. huttiense from feces, no template control, ATCC BAA-1705 and ATCC 700603, respectively. The sizes of the marker DNA are given on the left. 图 4 哈特草螺菌ERIC-PCR电泳图谱 Fig. 4 ERIC-PCR fingerprints of H. huttiense |
采用标准甲酸提取法制备样本,利用Bruker Biotyper 3.0软件对2株不同来源的哈特草螺菌和Bruker MALDI-TOF MS数据库中的草螺菌进行MSP聚类分析,以2株肺炎克雷伯菌标准菌株和9株不同病区的肺炎克雷伯菌临床分离株MSP聚类分析作为对照。MSP树状图结果显示,本例患者血液和粪便来源的哈特草螺菌位于同一节点,其衡量菌株同源性的指标distance level < 50(见图 5A),对照组菌株间差异较大,不同病区肺炎克雷伯菌临床分离株的distance level>100(见图 5B)。

|
| 图 5 MALDI-TOF MS对哈特草螺菌和肺炎克雷伯菌的MSP聚类分析树状图 Fig. 5 Dendrogram of MSP cluster analysis by MALDI-TOF MS for H. huttiense and Klebsiella pneumoniae |
采用Vitek 2 Compact细菌鉴定药敏仪N334和N335卡片对血液和粪便来源的草螺菌进行体外药敏试验,结果判断参考美国临床和实验室标准协会(Clinical and Laboratory Standards Institute, CLSI)M100第31版中表 2B-5其他非肠杆菌目细菌的最低抑菌浓度(minimum inhibitory concentration,MIC)折点[4]。结果显示,血液和粪便来源的哈特草螺菌药敏试验结果完全一致,对哌拉西林-他唑巴坦、替卡西林-克拉维酸、头孢他啶、头孢曲松、头孢吡肟、亚胺培南、美洛培南、妥布霉素、阿米卡星、环丙沙星、左氧氟沙星和甲氧苄啶-磺胺甲噁唑敏感,药敏试验中未发现抗菌药物耐药。
4 讨论草螺菌隶属于β -变形菌纲下属的伯克氏菌目,是一种非发酵、严格需氧的革兰氏阴性弯曲或螺旋杆菌,作为固氮细菌,主要栖息在植物的根茎中[5]。其与洋葱伯克霍尔德菌的系统发育和表型相似,目前自动生化鉴定系统无法鉴定草螺菌,导致其被广泛错误识别为洋葱伯克霍尔德菌,这可能导致哈特草螺菌的流行率被低估[6-7]。草螺菌与洋葱伯克霍尔德菌具有不同的耐药特点,后者具有多重耐药的特性,因此,当细菌被生化鉴定仪鉴定为洋葱伯克霍尔德菌,但对大部分抗菌药物敏感时,应怀疑其鉴定结果的准确性[1, 8],可结合菌体形态特征分析或使用氧化/发酵-多粘菌素-杆菌肽-乳糖(oxidation/fermentation-polymyxin-bacitracin-lactose,OFPBL)琼脂培养基对洋葱伯克霍尔德菌进行验证性培养[9-10]。
MALDI-TOF MS是一种新兴的软电离质谱技术,可用于绘制微生物的蛋白指纹图谱,并与已知微生物的标准蛋白指纹图谱数据库进行比较,以达到鉴定的目的[11]。本研究使用Microflex LT质谱仪搭载Bruker MBT DB5989数据库对哈特草螺菌鉴定进行重复性试验,鉴定结果为哈特草螺菌(分值2.137±0.074)或aquaticum草螺菌(分值1.916±0.136),依据布鲁克Microflex LT质谱仪使用手册,分值大于2.0作为可信结果。表明MALDI-TOF MS仅能准确鉴定至草螺菌属,无法鉴别哈特草螺菌和aquaticum草螺菌,这与既往研究报道的结论一致[8, 10, 12]。可见,MALDI-TOF MS可作为草螺菌属的快速鉴定手段,但达不到鉴定至种水平,数据库中草螺菌的图谱信息仍须丰富和完善。
16S rRNA基因测序对临床不常见的病原菌鉴定具有重要作用[13],但本研究使用16S rRNA基因测序不能区分哈特草螺菌、aquaticum草螺菌和camelliae草螺菌,基于草螺菌16S rRNA基因序列构建的系统进化树显示,草螺菌多数种的16S rRNA基因具有高度相似性,仍达不到种水平的鉴定,但足以鉴别草螺菌与洋葱伯克霍尔德菌,这与Regunath等[10]的研究结果一致。管家基因rpoB在伯克氏菌目某些细菌及近缘物种中的分辨能力高于16S rRNA基因[2],本研究尝试采用rpoB基因测序对该菌进行鉴定,发现哈特草螺菌rpoB基因序列具有特异性,在哈特草螺菌鉴定上优于16S rRNA基因测序,可将草螺菌鉴定至种水平,此鉴定方法亦被运用于分枝杆菌的某些菌种[14]。
草螺菌是一种条件致病菌,可在囊性纤维化患者的呼吸道定植,在免疫功能低下患者中引起菌血症和脓毒症,特别是癌症患者和接受造血干细胞移植的患者,并能引发院内聚集性感染[6, 15]。哈特草螺菌感染病例报道较为少见,在PubMed数据库以关键词“Herbaspirillum huttiense”进行检索,明确哈特草螺菌感染的病例仅5例,分别引起菌血症2例[1, 16]、败血症1例[17]、肺炎1例[8]和心内膜炎1例[18]。本研究与以往报道类似的是,从血液中分离出哈特草螺菌,而自动生化鉴定系统将其错误识别为洋葱伯克霍尔德菌,使用MALDI-TOF MS鉴定为草螺菌属,但无法区分哈特草螺菌或aquaticum草螺菌。不同的是,本文使用管家基因rpoB确定了哈特草螺菌的身份,使用左氧氟沙星和哌拉西林-他唑巴坦快速控制了感染,并通过试验确定血液中哈特草螺菌的来源。对患者多部位标本进行哈特草螺菌的检测,仅在粪便中检出少量哈特草螺菌,对血液和粪便来源的哈特草螺菌进行ERIC-PCR和MALDI TOF MS MSP聚类分析,ERIC-PCR指纹图谱显示两者的DNA带型完全一致,而MALDI TOF MS MSP树状图显示两者位于同一节点,且衡量菌株同源性指标distance level < 50,体外药敏试验结果也显示两者具有相同的耐药表型,提示两者高度同源。没有任何文献和证据表明哈特草螺菌可在肠道定植,本实验室在检出哈特草螺菌后1个月,未在其他住院患者各类样本中检出哈特草螺菌,结合患者食用自带食物后突发恶心、呕吐和高热的病史,本文推断患者这次感染是偶然性的,由食用哈特草螺菌污染的食物导致急性胃肠炎并诱发脓毒症,这与Chen等 [19]报道癌症患者食用甘蔗汁后出现草螺菌菌血症类似,表明癌症化疗患者摄入哈特草螺菌污染的食物可能会导致血流感染的发生。
体外药敏试验结果表明,哈特草螺菌对抗菌药物普遍敏感,这与既往报道一致[1, 8, 16-17]。目前,CLSI与欧盟药敏试验标准委员会(European Committee on Antimicrobial Susceptibility Testing,EUCAST)对草螺菌均无明确的折点,针对该菌感染的抗菌药物治疗尚未达成明确共识,经验性使用抗菌药物在哈特草螺菌感染中发挥了重要作用,本案例先后使用左氧氟沙星和哌拉西林-他唑巴坦治疗,效果显著。虽然既往研究报道并未出现多重耐药的哈特草螺菌,但哈特草螺菌基因组草图显示其包含69个耐药相关基因,且多重耐药相关基因占据主导地位[1]。可见,哈特草螺菌体外药敏试验是必要的,可指导临床对哈特草螺菌感染抗菌药物的使用和监测耐药的发生。
本研究的不足之处在于,未找到患者食用的不明食物残余,未能对食物进行哈特草螺菌的检测,仅依据患者血液和粪便分离的哈特草螺菌ERIC-PCR指纹图谱、MALDI-TOF MS MSP聚类分析、体外药敏试验结果、病史及相关文献进行分析;因条件限制,未采用PCR分型技术的金标准“脉冲场凝胶电泳(pulsed field gel electrophoresis,PFGE)”对患者血液和粪便来源的哈特草螺菌进行同源分析,选择采用本实验室能够开展的与PFGE相关性较高的ERIC-PCR和MALDI-TOF MS MSP聚类分析进行分析。
综上所述,本文从1例直肠腺癌术后化疗患者血液和粪便中分离出哈特草螺菌,使用VITEK 2 Compact细菌鉴定系统、MALDI-TOF MS、16S rRNA基因和rpoB基因测序进行鉴定,仅rpoB基因测序能准确识别为哈特草螺菌,因此,改进鉴定方法对加深对草螺菌的认识是必要的,进而准确记录草螺菌在人类宿主中的真实流行情况并制定预防措施。本案例患者血液中哈特草螺菌经实验证实与其粪便中检出的哈特草螺菌高度同源,结合病史可推断,哈特草螺菌污染食物后经胃肠道入血导致患者脓毒症的发生。本研究报道了几种检测方法对哈特草螺菌的鉴定能力以及哈特草螺菌罕见的感染方式,旨在加深临床和实验室人员对哈特草螺菌的认识。
| [1] |
Li X, Bao X, Qiao G, Wang L, Shi C, Chen S, Xu Y, Zheng M, Wang Z. First study of bacteremia caused by Herbaspirillum huttiense in China: a brief research report and literature review[J]. Front Cell Infect Microbiol, 2022, 12: 882827.
[DOI]
|
| [2] |
Tayeb LA, Lefevre M, Passet V, Diancourt L, Brisse S, Grimont PA. Comparative phylogenies of Burkholderia, Ralstonia, Comamonas, Brevundimonas and related organisms derived from rpoB, gyrB and rrs gene sequences[J]. Res Microbiol, 2008, 159(3): 169-177.
[DOI]
|
| [3] |
陈松建, 李亚辉, 王书伟, 张改, 李振江, 靳静, 王中全. 51株临床铜绿假单胞菌ERIC-PCR分型与噬菌体分型比较研究[J]. 中国病原生物学杂志, 2018, 13(11): 1193-1197. [CNKI]
|
| [4] |
Clinical and Laboratory Standards Institute. Performance standards for antimicrobial susceptibility testing. Approved guideline-31nd edition. CLSI document M100-Ed31[S]. Wayne, PA: CLSI, 2021.
|
| [5] |
Andreozzi A, Prieto P, Mercado-Blanco J, Monaco S, Zampieri E, Romano S, Valè G, Defez R, Bianco C. Efficient colonization of the endophytes Herbaspirillum huttiense RCA24 and Enterobacter cloacae RCA25 influences the physiological parameters of Oryza sativa L. cv. Baldo rice[J]. Environ Microbiol, 2019, 21(9): 3489-3504.
[DOI]
|
| [6] |
Spilker T, Uluer AZ, Marty FM, Yeh WW, Levison JH, Vandamme P, Lipuma JJ. Recovery of Herbaspirillum species from persons with cystic fibrosis[J]. J Clin Microbiol, 2008, 46(8): 2774-2777.
[DOI]
|
| [7] |
Ziga ED, Druley T, Burnham CA. Herbaspirillum species bacteremia in a pediatric oncology patient[J]. J Clin Microbiol, 2010, 48(11): 4320-4321.
[DOI]
|
| [8] |
Abreu-Di BM, Rodríguez-Czaplicki E, Sánchez-Hellín V. Herbaspirillum huttiense pneumonia in a patient with essential thrombocythaemia[J]. Rev Esp Quimioter, 2019, 32(1): 83-84.
[PubMed]
|
| [9] |
van Pelt C, Verduin CM, Goessens WH, Vos MC, Tümmler B, Segonds C, Reubsaet F, Verbrugh H, van Belkum A. Identification of Burkholderia spp. in the clinical microbiology laboratory: comparison of conventional and molecular methods[J]. J Clin Microbiol, 1999, 37(7): 2158-2164.
[DOI]
|
| [10] |
Regunath H, Kimball J, Smith LP, Salzer W. Severe community-acquired pneumonia with bacteremia caused by Herbaspirillum aquaticum or Herbaspirillum huttiense in an immune-competent adult[J]. J Clin Microbiol, 2015, 53(9): 3086-3088.
[DOI]
|
| [11] |
戴颖欣, 李敏. MALDI-TOF MS在临床微生物检验中的应用[J]. 检验医学, 2015, 30(2): 102-107. [CNKI]
|
| [12] |
贾明利, 杨婧, 赵斌. 质谱仪鉴定血流感染草螺菌1例及文献复习[J]. 东南国防医药, 2017, 19(2): 193-195. [CNKI]
|
| [13] |
曹敬荣, 高世超, 陈典典, 陈静, 闵嵘, 王培昌. 基于细菌16S rRNA基因扩增临床不常见病原菌的价值[J]. 中国感染控制杂志, 2016, 15(4): 222-226. [CNKI]
|
| [14] |
Kazumi Y, Mitarai S. The evaluation of an identification algorithm for Mycobacterium species using the 16S rRNA coding gene and rpoB[J]. Int J Mycobacteriol, 2012, 1(1): 21-28.
[DOI]
|
| [15] |
Chemaly RF, Dantes R, Shah DP, Shah PK, Pascoe N, Ariza-Heredia E, Perego C, Nguyen DB, Nguyen K, Modarai F, Moulton-Meissner H, Noble-Wang J, Tarrand JJ, LiPuma JJ, Guh AY, MacCannell T, Raad I, Mulanovich V. Cluster and sporadic cases of herbaspirillum species infections in patients with cancer[J]. Clin Infect Dis, 2015, 60(1): 48-54.
[DOI]
|
| [16] |
Liras Hernández MG, Girón de Velasco Sada P, Falces Romero I, Romero Gómez MP. Bacteremia caused by Herbaspirillum huttiense in a newborn[J]. Enferm Infecc Microbiol Clin (Engl Ed), 2019, 37(7): 491.
[DOI]
|
| [17] |
Liu C, Kwon MJ, Kim M, Byun JH, Yong D, Lee K. Septicemia caused by Herbaspirillum huttiense secondary to pneumonia[J]. Ann Lab Med, 2019, 39(3): 340-342.
[DOI]
|
| [18] |
Güngör AA, Demirdaǧ TB, Dinç B, Azak E, Yazal Erdem A, Kurtipek B, Özkaya Parlakay A, Sarı N. A case of infective endocarditis due to Herbaspirillum Huttiense in a pediatric oncology patient[J]. J Infect Dev Ctries, 2020, 14(11): 1349-1351.
[DOI]
|
| [19] |
Chen J, Su Z, Liu Y, Sandoghchian S, Zheng D, Wang S, Xu H. Herbaspirillum species: a potential pathogenic bacteria isolated from acute lymphoblastic leukemia patient[J]. Curr Microbiol, 2011, 62(1): 331-333.
[DOI]
|
 2023, Vol. 18
2023, Vol. 18


